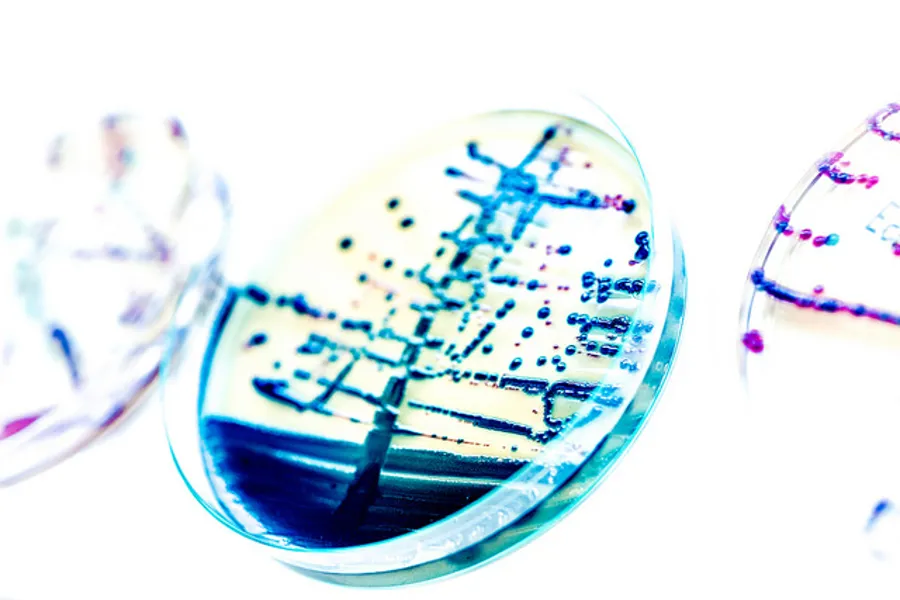
Bakterier.

FORSKNINGSGRUPPE
Antimikrobiell resistens (AMR)
Antimikrobiell resistens (AMR) utgjør en stor trussel mot den globale folkehelsen; gjennom forskning og økt kunnskap vil vi bidra i kampen mot AMR.
Hvis antibiotika skal forbli et globalt fellesgode for kommende generasjoner, må vi sette oss ambisiøse mål for arbeidet mot antibiotikaresistens
Bakgrunn for forskingsgruppen
Antimikrobiell resistens (AMR) utgjør en stor trussel mot den globale folkehelsen. På verdensbasis er det for 2021 estimert at ca 1,1-4,7 millioner mennesker døde på grunn av infeksjoner forårsaket av antibiotikaresistente bakterier. Dette tallet er forventet å øke til 10 millioner i 2050 dersom verdenssamfunnet ikke iverksetter effektive tiltak.
Forskning og samordnet globalt arbeid for å begrense videre utvikling og spredning av AMR, er høyt prioritert på agendaen til Verdens helseorganisasjon (WHO) og politiske ledere i mange land, inkludert Norge.
Helse Stavanger HF besluttet i 2016 en strategi for foretakets arbeid mot AMR, hvor forskning er ett av fire fokusområder. Forskningsgruppen vår ble etablert våren 2018, og vi har som mål å bidra med ny kunnskap i den globale kampen mot AMR.
Strategi
- Forskningen ved avdelingen skal være i front med tanke på mikrobiologisk diagnostikk og som en integrert del av avdelingens diagnostikk og metodeutvikling bidra til å styrke persontilpasset medisin, overvåkning og utbruddsoppklaring.
- Forskningen vår skal være av høy kvalitet på et internasjonalt nivå
Basert på utfordringsbilde og muligheter, og for å nå visjonen og målene våre, har vi valgt ut følgende tematiske satsingsområder som vil bli prioritert i strategiperioden 2025-2029.
Vi skal bygge videre på og etablere nye forskningsprosjekter innen fire tematiske satsingsområder:
Antimikrobiell resistens (AMR)
Det vil fokuseres på forskning knyttet til AMR som beskrevet i Helse Stavangers AMR-strategi og aktuelle handlingsplaner. Det skal bygges videre på etablerte lokale, regionale, nasjonale og globale nettverk, og pågående forskningsprosjekter.
Klebsiella pneumoniae
Det vil bygges videre på etablerte nasjonale og internasjonale forskningsnettverk og pågående prosjekter. Flere forskere ved avdelingen har gjennom flere år utviklet høy kompetanse knyttet til ulike aspekter ved K. pneumoniae som gjør at vi har gode muligheter for å kunne nå frem i konkurranse om eksterne forskningsmidler.
Legionella
Det vil bygges videre på etablerte nasjonale og europeiske nettverk, og referanselaboratoriet skal kontinuerlig utvikle og etablere nye metoder for diagnostikk og overvåkning, og relaterte forskningsprosjekter.
Mikrobiom
Mikrobiomforskning er svært relevant innenfor flere kliniske fagfelt, og flere forskere ved avdelingen er involvert i forskningsprosjekter som inkluderer mikrobiomstudier. Ved seksjon for FoU, vil det kontinuerlig arbeides for å etablere nye metoder for mikrobiomsekvensering og for å utvikle bioinformatisk kompetanse innen dette området.
Forskningsprosjekter
Pågående studier
Klebsiella pneumoniae – a key driver in the global spread of antimicrobial resistance and a target for new approaches in diagnostics, surveillance and alternative therapeutics (KLEB-GAP)
KLEB-GAP - Objectives and goals
The overall aim of the KLEB-GAP project is to explore Klebsiella pneumoniae (Kp) reservoirs using a first-in-kind One Health approach to develop new antimicrobial resistance diagnostics, innovative surveillance methods, and evaluate bacteriophages as treatment against multidrug resistant Kp. The project will explore the presence, persistence, and transmission of Kp and related mobile genetic elements (such as plasmids) and antimicrobial resistance determinants within and across human, animal, and marine reservoirs through advanced genomic and bioinformatic analyses of large prospectively collected samples (including the NOR-KLEB collections).
Mer informasjon om prosjektet finner du på nettsiden til nor-kleb.net: www.nor-kleb.net
ProRIDEmicro - Antimicrobial resistance, the gut microbiome, and infections in infants treated with probiotics in Tanzania.
ProRIDEmicro er et delprosjekt under ProRide (Use of Probiotics to Reduce Infections and Death and Prevent Colonization with Extended-spectrum beta-lactamase (ESBL) producing bacteria, among newborn infants in Haydom and surrounding area, Tanzania) som igjen er del av CAMRIA (Combatting Anti-Microbial Resistance with Interdisciplinary Approaches), det vestnorske senteret for antimikrobiell resistens. Andre prosjekter – CAMRIA.
ProRIDEmicro - objectives and goals
The main hypothesis of the ProRIDE trial is that probiotic supplement will significantly reduce morbidity and mortality in children up to six months of age in rural Tanzania, possibly mediated by increased colonisation resistance and reduced colonisation of ESBL-E and other pathogens in the gut, and thus reduced rates of endogenous infections, such as BSIs.
The primary objective of the Pro-RIDE trial is to study whether administration of probiotics during the first four weeks of life, compared to placebo, can reduce morbidity and mortality, and gut colonisation with ESBL-E and other pathogens during the first six months of life.
Prevalence of antimicrobial resistant bacteria among patients admitted to a rural referral hospital in Northern Tanzania
Stavanger University Hospital (SUH) and Haydom Lutheran Hospital (HLH) have a long lasting partnership governed by a Memorandum of Understanding. In 2016, the institutions agreed to include AMR-related activities, capacity building and be-lateral exchange of knowledge into the collaboration.
Knowledge of the AMR prevalence in a specific setting is substantially important when developing local clinical guidelines for treatment of infectious diseases. Most published studies are performed at large hospitals in densely populated areas. This study will provide prevalence data on ESBL, VRE and MRSA in a rural area of Tanzania, and gain knowledge on risk factors for ESBL, VRE and MRSA colonization in patients admitted to HLH. Furthermore, the study will provide new insight into the genetic epidemiology of AMR bacteria and the mechanisms of AMR development and spread at HLH and in the surrounding community. The results from HLH will reflect the AMR situation in the surrounding community of HLH and contribute with new data to the national AMR surveillance in Tanzania.
AMR-Haydom - objective and goal
To gain new knowledge on the AMR situation and to contribute to capacity building in a rural hospital in Tanzania.
Utprøving av antibiotika til barn med kronisk/langvarig hoste
Langvarig (protrahert) bakteriell bronkitt er den vanligste årsaken til kronisk våt hoste hos barn. AMIC studien er en randomisert kontrollert studie der vi studerer om behandling med antibiotika har effekt hos barn med kronisk våt hoste.
les mer i denne nettsaken: Har du en smårolling?👶 Forskningsteamet i AMIC-studien søker på nytt friske barn til kontrollgruppe
eller på prosjektets nettside: Utprøving av antibiotika til barn med kronisk / langvarig våt hoste - Helse Stavanger HF
Utvalg av tidligere studier
In The Norwegian Klebsiella pneumoniae study (NOR-KLEB), we are studying the population structure, virulence, and antimicrobial resistance (AMR) traits in human carriage and clinical isolates using large-scale whole genome sequencing. Furthermore, we focus on the burden of human disease caused by K. pneumoniae and the association of AMR, virulence, and clonal traits on patient outcome.
NOR-KLEB includes three sub-studies:
- a retrospective study including a historical collection of more than 1000 clinical K. pneumoniae isolates from most Norwegian hospitals;
- a prospective multicenter bacteremia study (NORKAB) with 13 collaborating Norwegian hospitals;
- a population based human carriage study using a large cohort of the Tromsø population study (The Tromsø 7 study).
Moreover, the project comprises international partnership with the University of Melbourne and Institùt Pasteur in Paris. As the research activities within NOR-KLEB are limited to the human sector, we recently established The Norwegian K. pneumoniae network, NOR-KLEB-NET (http://nor-kleb.net), which includes partners from the human, veterinary and marine sectors. NOR-KLEB-NET focus on the evolution and spread of AMR in K. pneumoniae from a “One Health” perspective, encompassing this pathogen’s ability to colonize and disseminate between humans, animals, food, and environment – and to cause clinical infections in humans and animals.
Mer informasjon finner du her: Utbrudd av multiresistent bakterie på en nyfødt-avdeling | Nye doktorgrader | UiB
Samarbeid
Forskningsgruppe for gastrokirurgi
- Kjetil Søreide MD PhD, professor og gruppeleder gastrokirurgisk forskningsgruppe
- Marina Aleexeva PhD, molekylærbiolog
- Kenneth Thorsen MD PhD, førsteamanuensis
Forskningsgruppe for barne og ungdomsmedisin
- Knut Asbjørn Alexander Øymar MD, professor og prosjektleder AMIC studien
- Ingvild Bruun Mikalsen MD PhD, førsteamanuensis og studielege AMIC studien.
- The Norwegian Klebsiella pneumoniae network (NOR-KLEB-NET): http://nor-kleb.net
- Nasjonal kompetansetjeneste for påvisning av antibiotikaresistens: https://unn.no/fag-og-forskning/k-res
- CAMRIA – Vestnorsk senter for forskning på antibiotikaresistens: CAMRIA – Combatting Anti-Microbial Resistance with Interdisciplinary Approaches
- London School of Hygiene and Tropical Medicine (LSHTM): www.holtlab.net
- Institùt Pasteur, Paris, France: https://research.pasteur.fr/fr/member/sylvain-brisse/
Publikasjoner
2023
- Within-patient and global evolutionary dynamics of Klebsiella pneumoniae ST17. Marit Andrea Klokkhammer Hetland, Jane Hawkey, Eva Bernhoff, Ragna-Johanne Bakksjø, Håkon Kaspersen, Siren Irene Rettedal, Arnfinn Sundsfjord, Kathryn Elizabeth Holt, Iren Høyland Löhr. Microbial genomics. 2023; doi: 10.1099/mgen.0.001005.
- Highly conserved composite transposon harbouring aerobactin iuc3 in Klebsiella pneumoniae from pigs. Håkon Kaspersen, Fiona Valerie Franklin-Alming, Marit A K Hetland, Eva Bernhoff, Iren H Löhr, Jatesada Jiwakanon, Anne Margrete Urdahl, Thongpan Leangapichart, Marianne Sunde. Microbial genomics. 2023; doi: 10.1099/mgen.0.000960.
- Population dynamics and characteristics of Klebsiella pneumoniae from healthy poultry in Norway. Håkon Kaspersen, Anne Margrete Urdahl, Fiona Valerie Franklin-Alming, Hanna Karin Ilag, Marit A. K. Hetland, Eva Bernhoff, Iren H. Löhr and Marianne Sunde. Front. Microbiol. 2023. doi: https://doi.org/10.3389/fmicb.2023.1193274
- Long-read sequencing for reliably calling the mompS allele in Legionella pneumophila sequence-based typing. Anne Vatland Krøvel, Marit A. K. Hetland, Eva Bernhoff, Anna Steensen Bjørheim, Markus André Soma, Iren H. Löhr Front. Cell. Infect. Microbiol., 15 May 2023 Sec. Bacteria and Host Volume 13 - 2023
- Co-localization of clinically relevant antibiotic- and heavy metal resistance genes on plasmids in Klebsiella pneumoniae from marine bivalves. Fredrik Håkonsholm, Marit A. K. Hetland, Iren H. Löhr, Bjørn Tore Lunestad, Nachiket P. Marathe. 19. july 2023 https://doi.org/10.1002/mbo3.1368
2022
- Legionella pneumophila in Municipal Shower Systems in Stavanger, Norway; A Longitudinal Surveillance Study Using Whole Genome Sequencing in Risk Management. Krøvel AV, Bernhoff E, Austerheim E, Soma MA, Romstad MR, Löhr IH. Microorganisms. 2022. doi: 10.3390/microorganisms10030536.
- Insights into the genetic diversity, antibiotic resistance and pathogenic potential of Klebsiella pneumoniae from the Norwegian marine environment using whole-genome analysis. Håkonsholm F, Hetland MAK, Svanevik CS, Lunestad BT, Löhr IH, Marathe NP. International Journal of Hygiene and Environmental Health. 2022; doi: 10.1016/j.ijheh.2022.113967.
- A nationwide genomic study of clinical Klebsiella pneumoniae in Norway 2001-15: introduction and spread of ESBLs facilitated by clonal groups CG15 and CG307. Fostervold A, Hetland MAK, Bakksjø R, et al. . J Antimicrob Chemother. 2022;77(3):665-674. doi:10.1093/jac/dkab463
2021
- A nationwide genomic study of clinical Klebsiella pneumoniae in Norway 2001–15: introduction and spread of ESBLs facilitated by clonal groups CG15 and CG307
- Rapid high-resolution detection of colistin resistance in Gram-negative bacteria using flow cytometry: a comparison with broth microdilution, a commercial screening test and WGS
- Exploring Klebsiella pneumoniae in Healthy Poultry Reveals High Genetic Diversity, Good Biofilm-Forming Abilities and Higher Prevalence in Turkeys Than Broilers
- Gastrointestinal carriage of Klebsiella pneumoniae in a general adult population: a cross-sectional study of risk factors and bacterial genomic diversity
- Emergence and dissemination of antimicrobial resistance in Escherichia coli causing bloodstream infections in Norway in 2002–17: a nationwide, longitudinal, microbial population genomic study
2020
2019
- Microbial risk factors for treatment failure of pivmecillinam in community-acquired urinary tract infections caused by ESBL-producing Escherichia coli
- Susceptibility of Legionella pneumophila to antimicrobial agents and the presence of the efflux pump LpeAB
- Convergence of virulence and MDR in a single plasmid vector in MDR Klebsiella pneumoniae ST15.
- Use of microbiology tests in the era of increasing AMR rates– a multicentre hospital cohort study
2018
- Emergence and rapid global dissemination of CTX-M-15-associated Klebsiella pneumoniae strain ST307
- Performance of the EUCAST disc diffusion method and two MIC methods in detection of Enterobacteriaceae with reduced susceptibility to meropenem: the NordicAST CPE study
- Clinical and bacteriological efficacy of pivmecillinam treatment for uncomplicated urinary tract infections caused by ESBL-producing Escherichia coli: a prospective, multicentre, observational cohort study
2017
- Utfordringer med mikrobiologiske prøvesvar knyttet til antibiotikaresistens
- Norwegian patients and retail chicken meat share cephalosporin-resistant Escherichia coli and IncK/blaCMY-2 resistance plasmids
2016
2015
2023
- An Epidemiological Study of Aeromonas spp. Infections in Norway. Rohringer A., Syre H., Hyllestad S., Amato E. 19 july 2023, published in Austin Journal of Public Health and Epidemiology.
- Risk assessment and antibody responses to SARS-CoV-2 in healthcare workers, by Amit Bansal, Mai-Chi Trieu, Kristin GI Mohn, Anders Madsen, Jan Stefan Olofsson, Helene Heitmann Sandnes, Marianne Sævik, Hanne Søyland, Lena Hansen, Therese Bredholt Onyango, Camilla Tøndel, Karl Albert Brokstad, Heidi Syre, Åse Garløv Riis, Nina Langeland, Rebecca Jane Cox, 21. july 2023 published in Frontiers in Public Health, section Infectious Diseases: Epidemiology and Prevention.
2022
- Attitudes and self-efficacy towards infection prevention and control and antibiotic stewardship among nurses: A mixed-methods study
- Risk factors associated with severe disease in respiratory syncytial virus infected children under 5 years of age.
- The burden of hospital-attended influenza in Norwegian children..
- The Performances of Three Commercially Available Assays for the Detection of SARS-CoV-2 Antibodies at Different Time Points Following SARS-CoV-2 Infection. Syre H, Obreque MEB, Dalen I, Riis ÅG, Berg Å, Löhr IH, Sundal J, Kleppe LK, Vadla MS, Lenning OB, Olofsson JS, Mohn KG, Tøndel C, Blomberg B, Trieu MC, Langeland N, Cox RJ. Viruses. 2022; doi: 10.3390/v14102196
- External Quality Assessment of SARS-CoV-2 Sequencing: an ESGMD-SSM Pilot Trial across 15 European Laboratories. Wegner F, Roloff T, Huber M, et al. J Clin Microbiol. 2022;60(1):e0169821. doi:10.1128/JCM.01698-21
2021
- External quality assessment of SARS-CoV-2-sequencing: An ESGMD-SSM pilot trial across 15 European laboratories
- The burden of respiratory syncytial virus in children under 5 years of age in Norway
- Neuroborreliosis with severe mental confusion and thickening of cranial nerves
- Impact of the Rotavirus Vaccination Program in Norway After Four Years With High Coverage
- En mann i 80-årene med gangvansker og høy CRP-verdi | Tidsskrift for Den norske legeforening (tidsskriftet.no)
2020
- Twenty years of endophthalmitis: Incidence, aetiology and clinical outcome
- Covid-19-pandemien har vist at mikrobiologiske laboratorier må møte smitteutbrudd med bred diagnostisk kompetanse, høy testkapasitet og effektiv infrastruktur. En ny EU-forordning truer nå utbruddsberedskapen.
2019
2018
2017
- Rotavirus detection in bulk stool and rectal swab specimens in children withacute gastroenteritis in Norway
- Comparison of toxR and tlh based PCR assays for Vibrio parahaemolyticus
2016
2015
Medlemmer
Forskningsgruppen vår er satt sammen av leger som er spesialister eller under spesialisering innen infeksjonsmedisin, smittevern og/eller medisinsk mikrobiologi, molekylærbiologer, bioingeniører og bioinformatikere.
- Iren Høyland Löhr (MD PhD) - Leder av AMR forskningsgruppe, avdelingssjef (AMM SUS), avdelingsoverlege (AMM SUS), Førsteamanuensis (UiB)
- Eva Bernhoff (PhD) - Seksjonsleder FoU (AMM SUS)
- Aasmund Fostervold (MD) - Overlege (AMM SUS) og stipendiat (UiB)
- Heidi Syre (MD, PhD) - Overlege (AMM SUS)
- Monica R. Romstad (MD) - Overlege (AMM SUS)
- Marit Hetland (MSc) - Bioinformatiker (AMM SUS) og stipendiat (UiB)
- Mia Winkler (MSc) - Stipendiat (AMM SUS)
- Anne Vatland Krøvel (Dr.scient) - Legionella referansefunksjon (AMM SUS)
- Mona Lütcherath (MSc) - Molekylærbiolog (AMM SUS)
- Ragna-Johanne Bakksjø (MSc) - Molekylærbiolog (AMM SUS)
- Anna Steensen Bjørheim (MSc) - Bioinformatiker (AMM SUS)
- Celine B. Nilsen (MSc) - Ingeniør (AMM SUS)
- Marianne Bollestad (MD) - Overlege smittevern (SUS)
- Lars Kåre Kleppe (MD) - Overlege smittevern (SUS)